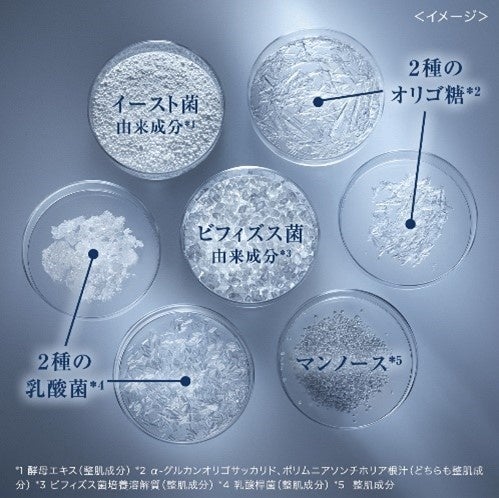

日本のランコム ミューズ戸田恵梨香さんがランコム研究員から美肌菌*1の秘密を学ぶ!戸田さんの美肌を保つスキンケア方法!ミューズとしての5年の歩みを振り返り「肌質の底上げにつながった」と笑顔も
【イベントレポート】「ランコム 美肌菌*¹ ステーション」 POP UPイベント開催記念~日本のランコム ミューズ 戸田恵梨香さんとの5年間の軌跡~

世界最大の化粧品会社ロレアルグループの日本法人である日本ロレアル株式会社(本社:東京都新宿区、代表取締役社長:ジャン-ピエール・シャリトン)のラグジュアリー化粧品ブランド「ランコム」は、9月30日(金)から10月2日(日)の3日間、スペシャルPOP UPイベント「ランコム 美肌菌*¹ ステーション」を開催する。本イベント開催を記念して、9月29日(木)に日本のランコム ミューズである戸田恵梨香さんをゲストに迎えたPRイベント『「ランコム 美肌菌*¹ ステーション」 POP UP イベント開催記念~ランコム ミューズ 5年目を迎える戸田恵梨香さんとの軌跡~』を開催した。
イベント冒頭には戸田さんに出演頂いたランコム No.1*2 美容液「ジェニフィック アドバンスト N (以下、ジェニフィック)」の2018年就任当初と2022年に撮影した最新のムービーの2種類を放映。ムービーを見た戸田さんは「当初と今回で全然印象が違いますね!今回のものは力強さが表現されている気がします。」と振り返った。また、ミューズに就任してから使い続けているという「ジェニフィック」については、「継続して使い続けることで肌質が底上げされましたね。私にとって手放せないお守りのような存在です。」と長年愛用するジェニフィックついての想いを熱く語る場面も。
また、ランコムのCSR活動の1つである、女性の教育支援を行う「Write Her Future」についての話題では、日本で力を入れているデジタルリテラシーに関する取り組みについて、「デジタルリテラシーについては弱い方なのですが、勉強しなければいけないスキルだなと思っています。今後もそういった学びの場が提供されると良いですね。」とランコムの取り組みに対して共感を示した。
次に、明日から開催されるPOP UPイベントについては、事前に体験したという戸田さんが印象的だったステーションを発表。「私の5年間の写真を展示していただいているエリアがあるんですが、写真をみると、あの時こんなことあったなと、自分の表情で歴史を感じて感慨深かったですね」とPOP UPイベントの魅力を語った。
続いて、ジェニフィック製品開発のキーパーソンである、ランコム サイエンティフィックディレクターのアニー・ブラック博士とのトークセッションを実施。日頃のスキンケアについて「今日はちょっと乾燥してるなとか、その時にあったスキンケアを行うようにしています。」という戸田さんに対し、アドバイスを求められたアニー博士は「戸田さんは本当にお肌が綺麗なので、これ以上アドバイスすることはないです!」と絶賛。そのうえで、「戸田さんのようなお肌を目指す方には、クレンジングを優しくすることを心がけてほしいです。また、ジェニフィックを朝晩2回使うのもおすすめですね」と戸田さんのような美肌を目指す人へアドバイスを送った。
最後に本日の感想を問われた戸田さんは、「5年ランコム製品を愛用させてもらっていますが、まだ新たな発見があるんだなと驚きました。自分の肌の調子を見ながら、これからもお守りのようにランコム製品を使っていきたいです。」と笑顔で語った。
*1皮膚常在菌叢(ランコムとしての定義)
*2 2019年9月~2022年8月までの国内美容液販売数比較に基づく。ランコム調べ。


【戸田さんPOP UP イベント来店の様子】


| 「ランコム 美肌菌*¹ ステーション」実施概要 |

・開催期間 :2022年9月30日(金)~2022年10月2日(日)
・開催時間 :9月30日(金)~10月1日(土) 11:00 open 20:00 close
10月2日(日) 11:00 open 19:00 close
(各日程、最終入場時間はclose時間の30分前までとさせていただきます。)
・開催場所 :スパイラルガーデン(〒107-0062 東京都港区南青山5-6-23)
・URL :https://www.lancome.jp/product/genifique-2209event/
・予約方法 :以下URLからランコム公式LINEをお友
達追加いただいたのち、フォームよりご予約いただけます。


STATION 1. 美肌菌*¹
ランコムNo.1*²美容液ジェニフィックが
着目した美肌菌*¹の秘密に迫るステーション。
1000種類以上ある美肌菌*¹のバランスは人それぞれ。
あなたの肌にも、あなただけの美肌菌*¹が存在することを
ご実感いただけます。

TATION 2. バリア機能
肌のバリア機能が、肌深く4段階まであることをゲームで
体感できるステーション。
4段階でレベルアップするゲームにチャレンジできます。
STATION 3. 7つの美肌成分
ジェニフィックに配合されている7つの成分を、
顕微鏡で見ることができるステーション。
中にはとても身近な成分も。
美肌菌*¹バランスの鍵となる成分を、のぞいて見てみましょう。

STATION 4. 7つの肌体感
ジェニフィックがアプローチする7つの肌体感を、知ることができるコーナー。目で見て分かる、手で触れて感じる7つの肌体感を、あなたの肌悩みから紐解きます。

STATION 5. 日本専用フォーミュラ
世界で唯一の「日本専用フォーミュラ」を、
お手元で実際に体験できるステーション。
みずみずしい肌馴染みの良さを、
特別なプロジェクションと一緒にお楽しみください。

STATION 6. 肌体験
ランコムが誇る肌体験サービスをご紹介。
別途事前予約いただくと、会場で体験ができます(満席)。
当日ご体験しない方も、会場内受付にて
全国のカウンターでの体験を予約できます。

STATION 7. CSR活動展示コーナー
ランコムのCSR活動をご紹介するステーション。
サステナブルな取り組み Grow Our Futureや
女性支援活動 Write Her Futureをご紹介。
また、イベント会場にランコム製品の対象空容器を
お持ちいただくと、オリジナルエコバッグをプレゼント
いたします。(数に限りがございます。)
【対象製品】
ジェニフィック シリーズ
・ジェニフィック アドバンスト N(美容液)30mL / 50mL / 115mL
・ジェニフィック アドバンスト デュアル コンセントレート N(集中美容液)20mL
・ジェニフィック アドバンスト アイセラム ライトパール アイ アンド ラッシュ(目もと用美容液)
20mL
・ジェニフィック アドバンスト アイ N(目もと用クリーム)15mL
・ジェニフィック アドバンスト アイクリーム(目もと用クリーム)15mL
クラリフィック シリーズ
・クラリフィック デュアル エッセンス ローション(化粧水)150mL / 250mL
・クラリフィック バランシング ウォータリーエマルジョン(乳液)75mL
・クラリフィック プランプ ミルキークリーム n(クリーム)50mL
タンイドル シリーズ
・タンイドル ウルトラウェア リキッド(リキッド ファンデーション)30mL
UV エクスペール シリーズ(日やけ止め用乳液)
・UV エクスペール トーン アップ ローズ 30mL / 50mL
・UV エクスペール トーン アップ n 30mL / 50mL
・UV エクスペール BB n 30mL / 50mL
・UV エクスペール BBⅡ n 30mL
・UV エクスペール クリア n 30mL / 50mL

特別インスタレーション
LANCÔME × ERIKA TODA
戸田恵梨香さんの日本ランコムミューズ就任5年目に際して、
ランコムと戸田恵梨香さんの軌跡を辿るインスタレーション。
日本で初めてのランコムミューズとなった戸田恵梨香さんの
数々のクリエイティブを振り返ります。

EXCLUSIVE GIFT
ご来場特典として下記をご用意しています。
①ジェニフィック7日間分に加えて
人気製品をたっぷりお試しできる豪華サンプルボックス。
さらに当たりが出たら、ジェニフィック1年分をプレゼント!
②ジェニフィック クリスマスコフレEC 先行販売

イベント会場内にて、ジェニフィック クリスマス コフレの先行販売を行います。会場内のスペシャルQRコードからアクセスいただくと、どこよりも早くご購入いただけます。また購入者様限定で、ジェニフィック アドバンスト ライトパール(目もと用美容液)のミニサイズ、ジェニフィック アドバンスト バイオセルロース マスク、オリジナル ポーチの豪華特典をその場でプレゼントいたします。
(全国発売は10/14(金)、EC先行発売10/7(金)です。
クリスマス コフレは9/30(金)以降に順次発送されます。)
【製品詳細】
・ジェニフィック クリスマスコフレ 30mL
ジェニフィック アドバンスト N (美容液/現品)30 mL
クラリフィック デュアル エッセンス ローション 10mL (美容化粧水/試供品)
クラリフィック ホワイト セラム 10mL [医薬部外品] (美白美容液/試供品)
オリジナル ギフトボックス
・ジェニフィック クリスマスコフレ 50mL
ジェニフィック アドバンスト N (美容液/現品) 50mL
クラリフィック デュアル エッセンス ローション 10mL (美容化粧水/試供品)
クラリフィック ホワイト セラム 10mL [医薬部外品] (美白美容液/試供品)
クラリフィック プランプ ミルキークリーム n 15mL (クリーム/試供品)
オリジナル ギフトボックス
■「ジェニフィック アドバンスト N」について
「ジェニフィック アドバンスト N」は、美肌菌*¹の変化に着想を得て誕生しました。美肌菌*¹は誰もが肌に生まれ持つマイクロバイオーム(皮膚常在菌叢)のことで、肌のバリア機能を強化し、回復を促す重要な役割を果たしています。ランコムの15年にわたる美肌菌*¹ 研究を経て、2019年9月に進化しました。
スキンケアステップを重ねる日本の方のために開発されたみずみずしい日本専用フォーミュラは、次のスキンケアステップをサポートします。朝・夜2回、洗顔後のまっさらの肌にご使用いただくことで、浸透感の良い肌に。毎日のスキンケアで「すばやい回復力」を目指します。
発売以来10年連続でランコムNo.1*²美容液に輝き、リピート率もNo.1*³のジェニフィックは、多くの方に愛され続けています。毎日のマスク生活でトラブルが起きやすい昨今。「すばやい回復力」を目指したジェニフィックで強さみなぎる、輝き溢れる肌へ。
*¹ 皮膚常在菌叢(ランコムとしての定義)
*² 2019年9月~2022年8月 国内美容液売り上げ本数に基づく。ランコム調べ。
(発売当初からリニューアル前の製品を含む。)
*³ 2019年10月~2020年3月美容液国内リピート率に基づく。ランコム調べ。
■ランコムについて(https://www.lancome.jp)
日本ロレアルが有する人気高級ブランド。
1935年、ランコムは、先見の明を備えたパイオニア、アルマン・プティジャンにより、フレンチ エレガンスの精神とテイストを世界中に伝えることを目指して創立され、瞬く間に美の真髄を体現するブランドへと成長しました。ランコムは今、かつてないほど、すべての女性たちが、年齡や肌の色に関係なく、自らの美しさと女性らしさを花開かせ、その魅力を最大限に発揮できるよう願っています。
ランコムは135ヵ国で事業を展開し、世界各国の販売店で約2万人のビューティーアドバイザーたちが、洗練されたサービスとブランドを象徴する製品をお届けしています。ランコムは、科学の専門知識と女性のニーズを叶える想いをひとつに融合させ、スキンケア、メイクアップ、フレグランスが互いに補完しあうユニークなイノベーションを創造し続けています。ランコムは、全ての女性が自信を持って輝き、より幸福な未来を切り拓けるように応援しています。この考え方を広く伝えるため、ランコムはこれまでカリスマ性と大きな成功を手に入れた以下の女性たちにブランドの代弁者をお願いしてきました。ジュリア・ロバーツ、ペネロペ・クルス、ルピタ・ニョンゴ、リリー・コリンズ、イザベラ・ロッセリーニ、ゼンダイヤ・コールマン、アマンダ・サイフリッド。
NGO団体「Care(ケア)」とのパートナーシップにより、ランコムは、グローバル規模の支援プログラム「Write Her Future」をスタートしました。この取り組みは、世界各国における女性の識字(リテラシー)率向上を目指しており、日本においては2021年9月にデジタルリテラシー向上を目指すプロジェクトを開始し活動を続けています。
■日本ロレアルについて(http://www.nihon-loreal.jp/)
ロレアルは1963年から日本で事業を開始し、1996年に日本法人である日本ロレアル株式会社が設立されました。2021年末時点での社員数は2,270人、2022年6月現在の取り扱いブランドは18です。化粧品の輸入、製造、販売、マーケティングを行っています。
このプレスリリースには、メディア関係者向けの情報があります
メディアユーザー登録を行うと、企業担当者の連絡先や、イベント・記者会見の情報など様々な特記情報を閲覧できます。※内容はプレスリリースにより異なります。
すべての画像